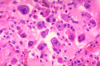
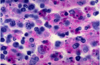
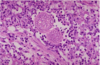

HIV DSA Flashcards
(48 cards)

200> X > 50
between 200 and 50 CD4
Pneumocystis Jirovecii
Obligate extracellular fungus that has silver stained cysts in tissues. Can cause interstitial pneumonia in AIDS patients. Causes death of type I pneumocytes and subsequent overproliferation of type II pneumocytes.
Acid fast rods that are obligate aerobes. Nonchromogen. Highly resistant to desiccation and many chemials including NaOH. When do you tx pts for this and with what?
mycobacterium avium
CD4 < 50
tx w/ macrolides+ethambutol prophylactically
Acid fast rods that are obligate aerobes. Contains mycolic acids highly resistant to desiccation and many chemials including NaOH. Causes pulmonary, GI and disseminated disease. Presents in AIDS patients, cancer patients, and those with chronic lung disease. Nonchromogen. Treat AIDS patients prophylactically for this with a CD4 of less than 50. Macrolide plus ethambutol.
Acid fast rods that are obligate aerobes. highly resistant to desiccation and many chemials including NaOH. Photochromogen.
how would you treat this patient and when?
mycobacterium Kanasii
Cavitary lesions in the apical regions of the lungs, presents almost identically to TB in AIDS pt
Acid fast rods that are obligate aerobes.
Contains mycolic acids highly resistant to desiccation and many chemials including NaOH. Causes pulmonary, GI and disseminated disease.
Presents in AIDS patients, cancer patients, and those with chronic lung disease.
Photochromogen.
Treat AIDS patients prophylactically for this with a CD4 of less than 50. Macrolide plus ethambutol.
Large dsDNA enveloped icosahedral virus that forms intranuclear inclusion bodies and can establish latency. reservoir in humans, can turn on VEGF. often confused with another condition.
Kaposi Sarcoma
Large dsDNA enveloped icosahedral virus. Forms intranuclear inclusion bodies and can establish latency. reservoir in humans and can turn on VEGF, playing a role in deveoping Kaposi sarcoma. Need to differentiate from bacillary angiomatosis in AIDS patients.

Toxoplasma gondii Cause of disease due to cat feces in pregnant women. Can cross the placenta
Hint: it’s not Kapsoi. What is the causative pathogen’s morphology?

bacillary angiomatosis: a form of angiomatosis associated with bacteria of the Bartonella genus
Gram negative rod that is the causative agent of cat scratch fever (bacillary angiomatosis in AIDS patients).

Cryptococcus neoformans
Encapsulated yeast that is monomorphic.
Found in soil enriched with pigeon droppings.
Diseases such as hodgkin’s lymphoma and AIDS can dispose to infection (leading cause of meningitis in these disease states).
NOT the leading meningitis cause in transplant patients. (that would be Listeria monocytogenes).
Acid fast rods that are obligate aerobes. Nonchromogen

Mycobacterium avium intracellular (a complex formed by myco intracellulare and myco avium)
Acid fast rods that are obligate aerobes. Contains mycolic acids highly resistant to desiccation and many chemials including NaOH. Causes pulmonary, GI and disseminated disease. Presents in AIDS patients, cancer patients, and those with chronic lung disease. Nonchromogen. Treat AIDS patients prophylactically for this with a CD4 of less than 50. Macrolide plus ethambutol.

hairy leukoplakia (EBV)

vaginal candidiasis
pharm to tx pneumocystis jirovecii
tmp/smx bactrim
Trimethoprim/sulfamethoxazole
pharm to tx toxoplasma gondii
tmp/smx
MAC tx
azithromycin
TB tx
TST >/= 50
patches of creamy white exudate with reddish brown base cover the mucous membranes of the mouth
oral thrush
vaginal itching, cottage cheese appearing white clumbs affixed to vaginal wall
vaginal candidiasis
burning substernal pain, worse with swallowing. patches of creamy white exudate on walls of esophagus
candida: esophagitis
seizures, gait instability, weakness, sensory loss, no meningeal signs
toxoplasma gondii
most common CNS infection in AIDS patients
pt has fever, shortness of breath, non-productive cough.
flying saucer appearing morphology. what kind of pneumonia do we expect to see with this agent?
Pneumocystis Jirovecii
most common opportunistic infection of AIDS patients:
PCP infection
pneumocystis jirovecii
fever, night sweats, weight loss, often diarrhea, elevated liver function tests. often classified as “FUO” fever of unknown origin. Not TB.
MAC
what would this expect to cause in a pt with HIV and when?
CMV retinitis; CD4 < 50

HHV-8
Kaposi’s sarcoma
meningitis, headache, nausea, confusion, staggering gait, sometimes cranial nerve deficits: what does this hint in an HIV patient?
cryptococcus neoformans: major manifestation is meningoencephalitis. commonly seen in pigeon doppings. 75% cases occur in immunocompormised pts.